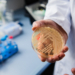
O ciupercă mortală rezistentă la medicamente se răspândește într-un ritm îngrijorător

În cele 12 luni care au trecut de la invadarea Ucrainei de către Rusia, un eveniment care a perturbat pieţele energetice din întreaga lume, importurile Chinei de petrol, gaze naturale şi cărbune din Rusia au crescut cu peste 50%.
Sumele cheltuite de Beijing pentru energia din Rusia – petrol şi produse petroliere, cărbune, gaze naturale – în perioada februarie 2022 – februarie 2023 au urcat până la 88 de miliarde de dolari, de la 57 de miliarde de dolari în precedentele 12 luni, potrivit cifrelor publicate de administraţia vamală chineză, scrie Agerpres, preluând Bloomberg.
Datele arată că Rusia primeşte o sursă fiabilă de finanţare pentru maşinăria sa de război, în pofida sancţiunilor internaţionale, în timp ce China, care are un mare apetit pentru energie, obţine mari cantităţi de combustibili fosili, deseori la preţuri reduse.
Rusia, principalul furnizor de petrol brut al Chinei
Cifrele oficiale mai arată că, în perioada februarie 2022 – februarie 2023, Rusia a fost principalul furnizor de petrol brut al Chinei, depăşind Arabia Saudită. A fost, de asemenea, al doilea mare furnizor de cărbune, după Indonezia, şi al treilea pentru gaze naturale lichefiate, după Australia şi Qatar.
De remarcat că datele privind importurile de gazele naturale lichefiate ale Chinei nu includ şi volumele de gaze naturale ruseşti livrate prin conducte, date pe care China a încetat să le mai facă publice la începutul acestui an.
Importurile de aluminiu rusesc s-au dublat
Importurile Chinei de petrol rusesc au urcat la 89,3 milioane de tone, în perioada februarie 2022 – februarie 2023, de la 78,4 milioane de tone în precedentele 12 luni.
RelatedPosts
Achiziţiile de gaze lichefiate din Rusia ale Chinei au crescut cu 52%, până la 6,86 milioane de tone, în timp ce importurile de cărbune au crescut cu 33% până la 76,4 milioane de tone.
Tot conform datelor oficiale, în perioada februarie 2022 – februarie 2023, importurile Chinei de aluminiu rusesc aproape s-au dublat (creştere de 94%), până la 538.607 tone, ceea ce înseamnă că Beijingul a susţinut producţia rusească de aluminiu într-un moment în care sancţiunile internaţionale au oprit schimburile comerciale ale Rusiei cu cumpărătorii săi obişnuiţi de aluminiu din Europa şi alte părţi.
 Acasa
Acasa






























 Declinare de responsabilitate pentru comentarii
Declinare de responsabilitate pentru comentarii